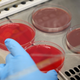
'.$caption.'

Gletscherschwund ist «Frage des Überlebens» für Menschheit
20.03.2025 - 07:00:41 | dpa.deWeltweit schrumpfen viele der rund 275.000 Gletscher mit alarmierender Rate, sowohl im Gebirge als auch in den polaren Regionen. Zwischen 2012 und 2023 war der Schwund 36 Prozent größer als in den zehn Jahren davor, zeigt eine Studie der Schweizer Universität Fribourg. Hauptursache ist der menschengemachte Ausstoß von Treibhausgasen, die das Klima erwärmen. Um die Menschheit wachzurütteln, haben die Vereinten Nationen den 21. März neu zum Welttag der Gletscher erklärt.
Einige der gravierendsten Folgen des Gletscherschwundes:
Trinkwasser
Gletscherschmelzwasser ist ein entscheidender Bestandteil zur Versorgung der Weltbevölkerung mit Trinkwasser. Sie als Trinkwasserquellen zu erhalten, sei eine Frage des Überlebens für die Menschheit, warnt Gletscherforscher John Pomeroy von der kanadischen Universität Saskatchewan.
Gletscher sind Reservoire, Schmelzwasser nährt etwa in heißen Jahreszeiten Flüsse, die auch zur Bewässerung von Landwirtschaft genutzt werden. Zunächst wächst die Wassermenge durch die schmelzenden Gletscher, aber in Europa könnte der Höhepunkt schon überschritten sein, sagt Gletscherexperte Daniel Farinotti, Professor an der Universität ETH in Zürich und der Eidgenössischen Forschungsanstalt für Wald, Schnee und Landschaft (WSL).
«Die 273 Milliarden Tonnen Eis, die in einem einzigen Jahr (durch Gletscherschmelze) verloren gehen, entsprechen dem Wasserverbrauch der gesamten Weltbevölkerung während 30 Jahren, wenn man von drei Litern pro Person und Tag ausgeht», zitiert die Universität Zürich den Glaziologen Michael Zemp.
Am Eingang des Genfersees in der Schweiz macht Wasser des Rhone-Gletschers über das Jahr gerechnet etwa 15 Prozent aus, sagt Farinotti. In Europa stammt ein Großteil des Trinkwassers aus Grundwasser, das vor allem aus Niederschlägen gespeist wird. Welche Rolle Schnee- und Eisschmelze genau für das Grundwasser spielen, wird noch erforscht.
Meeresspiegelanstieg
Die Gletscher haben weltweit seit dem Jahr 2000 jedes Jahr rund 273 Milliarden Tonnen Eis verloren, heißt es in einer neuen Studie unter Leitung der Universität Zürich. Das habe 18 Millimeter zum Meeresspiegelanstieg beigetragen. Darin ist nicht das Schmelzen der kontinentalen Eisschilde Grönlands und der Antarktis berücksichtigt.
Der jährliche Meeresspiegelanstieg hat sich verglichen mit dem durchschnittlichen Wert des 20. Jahrhunderts seit 2006 auf rund 3,6 Millimeter mehr als verdoppelt, berichtete die US-Klimabehörde Noaa 2023. Tendenz: steigend. Neben Gletscher- und Eisschmelze trägt dazu auch die Ausdehnung des Meerwassers durch Erwärmung bei. Die Noaa geht davon aus, dass der Meeresspiegel Ende des Jahrhunderts rund 30 Zentimeter höher liegt als im Jahr 2000, selbst, wenn die Treibhausgasemissionen in den kommenden Jahrzehnten auf relativ niedrigen Niveau bleiben.
Bei höherem Meeresspiegel werden Inseln und Küstengebiete überspült, Wohngebiete unbewohnbar und Ackerflächen zerstört. Salziges Meereswasser kann Süß- und damit Trinkwasserquellen kontaminieren, Hurrikans richten bei höherem Wasserstand höhere Schäden an.
Ozeanzirkulation
Das milde Klima in Europa und die Niederschlagsverteilung weltweit wird entscheidend geprägt durch den Golfstrom, Teil der Atlantischen Umwälzströmung (Amoc). Er bringt warmes Ozeanwasser nach Norden, wo es abkühlt und sinkt und so die atlantische Strömung in Gang setzt. Der Weltklimarat IPCC hat gewarnt, dass ein Kollaps der Zirkulation durch unerwartet große Mengen an Schmelzwasser aus polaren Gletschern ausgelöst werden könnte.
Eine neue Studie im Fachmagazin «Nature» legt nahe, dass die Amoc womöglich zwar nicht vollständig verschwindet, aber deutlich schwächer wird. «Ob es dann am Ende ein Kollaps oder eine sehr starke Abschwächung ist, macht für die Auswirkungen dieser Veränderung am Ende kaum keinen Unterschied», berichtet aber Jens Terhaar, der an der Universität Bern unter anderem das Ökosystem des Arktischen Ozeans modelliert. «Beides wäre mit extremen Folgen verbunden und man sollte alles unternehmen, um dies zu vermeiden.»
Biodiversität
Im Gebiet der Berggletscher verändert sich die Biodiversität dramatisch, wenn das Eis schmilzt und die Temperaturen steigen. Wärmeempfindliche Pflanzen und Tierarten müssen höher wandern. Kaltwasserbewohner in Flüssen sind bedroht, wenn ihr Habitat nicht mehr von Gletscherwasser gekühlt wird.
«Manche Arten mögen es nicht, wenn das Wasser warm wird, und Flüsse könnten so weit austrocknen, dass Fische und andere aquatische Lebewesen keine Chance fürs Überleben haben», sagt Farinotti. Das Schweizer Wasserforschungsinstituts Eawag schreibt, womöglich müssten empfindliche Flussbewohner von Menschen auch in höhere Lagen umgesiedelt werden. Dort müssten sie auch geschützt sein. Von Gletschern freigegebene Gebiete dürfen also nicht sämtlich als Freizeitgebiet oder zur Produktion von Energie durch Wasserkraft genutzt werden.
Neue Bakterien oder Pilzarten
Im Gletschereis werden immer wieder unbekannte Mikroorganismen entdeckt. Was passiert, wenn das Eis schmilzt? Chinesische Forschende dokumentierten in Berg- und Polargletschern DNA von mehr als 10.000 Virenarten, die nach ihren Angaben aber keine große Gefahr für die öffentliche Gesundheit darstellen. In Schweizer Gletschern und Permafrost hat Beat Frey vom WSL mit Kollegen zehn neue Bakterienarten und eine neue Pilzart entdeckt.
Diese Organismen können Aufschluss über vergangene Klimaveränderungen liefern. Untersucht wird, ob sie womöglich auch im Kampf gegen antibiotikaresistente Keime nützlich sein können. Frey und Kollegen fanden zudem, dass manche Bakterien bestimmte Kunststoffe bei sehr niedrigeren Temperaturen abbauen konnten. «Unsere langfristige Vision ist, eine Lösung für einige globale Probleme zu finden», sagt Frey dem Portal swissinfo.ch.